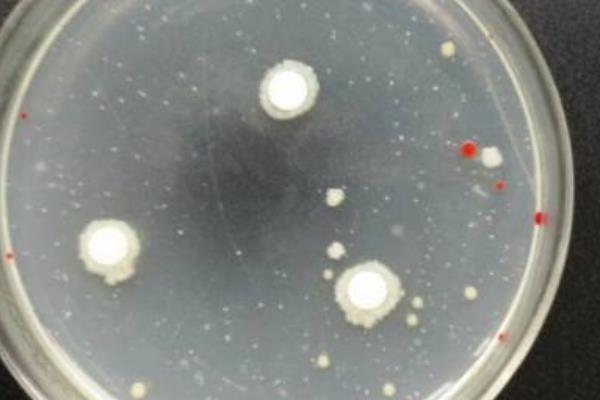
菌种保存的方法有哪些，菌种传代操作规程

菌种保存的方法有斜面低温保藏法、液体石蜡覆盖保藏法、沙土保藏法、滤纸保藏法、甘油管保存法、冷冻干燥保存法。1、斜面低温保藏法:将菌种接种到适合的固体斜面培养基上,用油纸将棉塞部分包扎好,然后转移至2-8℃的冰箱中进行保存。2、液体石蜡覆盖保藏法:使用液体石蜡将斜面菌覆盖住,使其和空气隔绝。
一、菌种保存的方法有哪些
1、斜面低温保藏法
(1)将菌种接种到适合的固体斜面培养基上,等到菌种充分生长过后,使用油纸将棉塞部分包扎好,然后转移至2-8℃的冰箱中进行保存。
(2)如果是霉菌、放线菌及有芽孢的细菌,一般可以保存2-4个月左右,需要移种一次。如果是酵母菌,一般可以保存2个月左右,需要每个月移种一次。

2、液体石蜡覆盖保藏法
(1)将液体石蜡装在三角烧瓶中,并使用棉塞塞好,用牛皮纸进行包扎,然后在0.1MPa,121.3℃的环境下灭菌30分钟左右,接着将其放置在40℃的温箱之中,将水汽蒸发掉。
(2)将需要保藏的菌种,用适合的斜面培养基进行培养,得到健壮的孢子或者是菌体。
(3)使用灭菌过的吸管将液体石蜡吸出,注入斜面上,用量为高出斜面顶端1cm左右为宜。
(4)将试管直立,放置在低温或者是室温之下进行保存。
(5)霉菌、放线菌、芽孢细菌可以保藏2年以上不死,酵母菌可以保藏1-2年,一般无芽孢细菌可以保藏1年,脑膜炎球菌可以保藏3个月左右(37℃环境下)。

3、沙土保藏法
(1)准备好河沙,加入10%稀盐酸,然后加热煮沸30分钟左右,将里面的有机质去掉,然后将酸水倒掉,用自来冲洗至ph为中性,接着烘干,过筛(40目筛子),去掉粗颗粒。
(2)准备好非耕作层的不含腐植质的瘦黄土或红土,浸泡洗涤数次,直至ph为中性,然后烘干,碾碎,过筛(100目筛子),去掉粗颗粒。
(3)将沙和土按照2:1的比例混合,装入试管或者是安瓿管中,塞好棉塞,在1212℃的环境下灭菌30分钟左右。
(4)将菌种在斜面培养基中培养,得到健壮的菌体,然后向斜面培养物中注入3-5ml无菌水,洗下细胞或孢子制成菌悬液。
(5)使用灭菌过的吸管吸取菌悬液,然后均匀滴入沙土管中(0.2-0.5ml/管)。如果是放线菌或霉菌,可以直接挑取孢子拌入沙土管中。
(6)真空抽去沙土管中的水分。
(7)将沙土管用火焰熔封,然后存放在低温(4-6℃)干燥处保藏,或者是将沙土管用牛皮纸或塑料纸包好,放置在干燥器内保存。保存期间,每隔6个月左右检查一次菌种存活性。

4、滤纸保藏法
(1)准备好滤纸条(0.5×1.2cm),安瓿管(0.6×8cm),然后每个安瓿管放置1-2张滤纸条,塞上棉塞,在0.1MPa,121℃的环境下灭菌30分钟左右。
(2)将菌种在适合的斜面培养基上培养,得到健壮的菌体。
(3)在灭菌培养皿中滴加1-2ml的灭菌脱脂牛乳,并取数环菌苔在牛乳内混合均匀,制成浓悬液,然后使用镊子从安瓿管中取出滤纸条,浸入菌悬液中,吸饱后,放回安瓿管中,塞上棉塞。
(4)将安瓿管放入干燥器中(内有五氧化二磷作吸水剂),并用真空泵抽气至干。
(5)将棉花塞入管内,用火焰熔封,然后放置在低温环境下保存。
5、甘油管保存法
(1)准备好80%的甘油,然后进行高压蒸汽灭菌处理。
(2)将菌种在适合的斜面培养基上培养,并使用无菌水注入,制成成高浓度的菌悬液。
(3)取出1ml的甘油和菌液混合均匀,让甘油的浓度变为10-30%左右,然后放置在零下70℃的环境下进行保存。

6、冷冻干燥保存法
在低温下快速冻结细胞,然后在真空条件下进行干燥,让微生物的生长和酶活动停止,同时为了保证细胞在冷冻和水分升华的过程中不受损害,应当使用保护剂来制备细胞细胞悬液(菌在冻结和脱水过程中起到保护作用的溶质),通过氢键和离子键对水和细胞所产生的亲和力来稳定细胞成分的构型。

二、菌种传代操作规程
1、点燃酒精灯,在火焰旁的上方灼烧接种环。
2、将原有的菌种斜面培养基(菌种管)和待接种的新斜面培养基(接种管)用左手的拇指、食指和中指夹住,菌种管在前,接种管在后,然后斜持试管(45°),让试管内斜面向上,两个试管的口子平齐。
3、右手在火焰旁边转动两管的棉塞,然后右手拿着接种环的柄端,垂直将接种环在火焰上灼烧,顶端的环必须烧红,而且凡是接种时进入试管的部分,均应通过火焰灼烧。
4、使用右手的小指和手掌之间以及无名指和小指之间,将两管的棉塞拔出,拿住,然后将试管在火焰上通过。
5、将接种环插入菌种管内,接触无菌苔生长的培养基,待冷后,从斜面上挑取少许菌苔,然后迅速插入接种管,在斜面上轻轻划线接种(由下而上划直线,然后由下往上划曲线)。
6、接种完毕后,将管口通过火焰灭菌,并将棉塞塞上。
三农问答